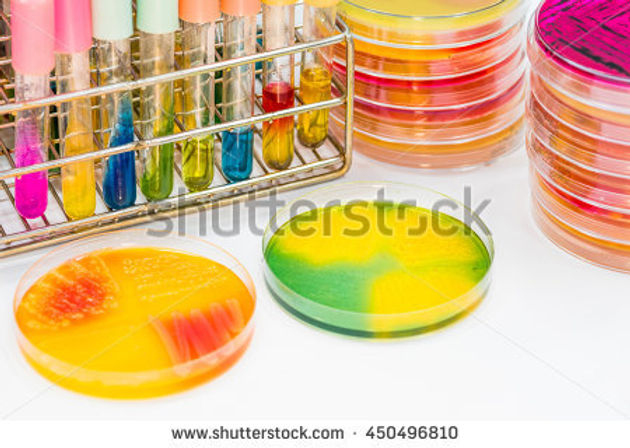
stock-photo-the-buffer-in-beaker-and-bacteria-culture-growth-on-selective-media-plate-biochem-test-k

SEHAT LAB & BLOOD BANK TIMERGARA صحت لیب اور بلڈ بینک تیمرگرہ
Laboratory, Blood Bank, Radiology & Pharmacy Services لیبارٹری، بلڈ بینک، ریڈیوولوجی اور فارمیسی خدمات
Ph: 03000820557
![]() | ![]() | ![]() |
|---|---|---|
![]() | ![]() | ![]() |
Clinical Chemistry:
(the study of chemical and biochemical mechanisms of the body in relation to disease, mostly through the analysis of body fluids such as blood or urine). Focused on patient safety, we provide accurate, precise and reliable test results for a wide range of complex test menus, performed on our state of the art equipment, monitored by qualified and credentialed laboratory technologists, with a robust internal quality control programme as well as an external quality control programme that complies with ISO (International Organization for Standardization), CLSI (Clinical Laboratory Standards Institute) guidelines for patient safety.
Currently the test menu includes more than 200 tests performed on automated analyzers for routine chemistries and immunoassays in addition to the many specialized areas of laboratory testing including manual testing, therapeutic drug testing and toxicology, provocative testing, biochemical genetic laboratory, atomic absorption and protein chemistries and special chemistries.


Hemostasis (Hematology):
(testing for blood clotting). We get referrals cases all over the Dir for the diagnosis of inherited and acquired bleeding disorders. We have an automated system for CBC (complete blood count) and hematologist for peripheral blood smear. Quality assurance as practiced in our laboratory results in precise and accurate reports.
Molecular Pathology:
(the study and diagnosis of disease through the examination of molecules within organs, tissues or bodily fluids). Our test reporting is unique compared to other laboratories in Dir. Reports is provided in the context of other laboratory data and clinical findings, where available. Quality controls are included in each test so that both positive as well as negative samples can be reported with reliability. Any possible discrepancies or borderline results are retested without extra cost to the patient.

Microbiology:
(the study of microscopic organisms, such as bacteria, viruses, and fungi). We are the only Microbiology Laboratory in Dir that has been given the status of a Lab for the diagnosis of expertise in all specialties such as Bacteriology, Mycology, Virology, Parasitology and Infection Control. Our Qualified staffs are sought after for consultations on antimicrobial therapy, antibiotic stewardship and infection control throughout the Dir. We follow international standard protocols for reporting strategies. We have a specialized set-up for performing Water Culture. Our laboratories are critically monitored and quality controlled with a wide range of microbiology media and reagents of international standards.
Histopathology:
(the examination of a biopsy or surgical specimen by a pathologist, after the specimen has been processed and histological sections have been placed onto glass slides). Histopathology reports are not machine produced. They require pathologists with vast knowledge, sub specialization skills and experience. Histopathology cases are referred to Shifa Lab Islamabad. Where daily departmental consultation conferences are held to discuss difficult and challenging cases. We ‘go all the way’ to reach accurate and conclusive diagnosis in difficult and challenging cases utilizing all ancillary techniques available without putting additional financial burden on the patient. Different types of cancers have different types of treatment. Therefore accurate diagnosis is essential.







